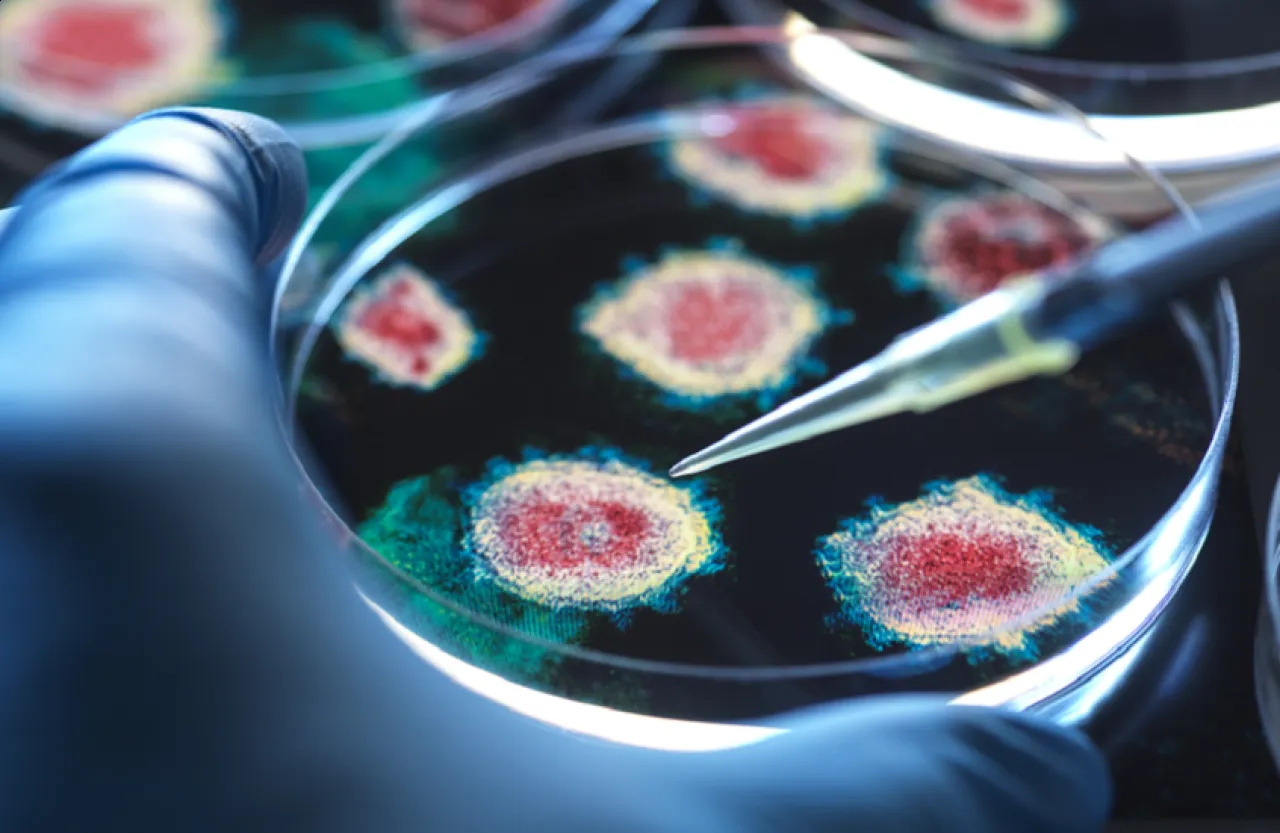
بمشاركة عربية تجربة دولية عالمية لمواجهة خطر الفيروسات المتجمدة

خبرني - استخدمت منظمة الصحة العالمية "فيروسا خياليا" لمحاكاة جائحة مستقبلية افتراضية مصدرها جثة ماموث متجمدة، وذلك ضمن تمرين دولي لاختبار جاهزية العالم لمواجهة الأوبئة القادمة.
وأطلقت المنظمة على السيناريو المفترض اسم "تمرين بولاريس"، وشارك فيه خبراء من 15 دولة لمواجهة تفشّ افتراضي لفيروس يسمى "جدري الماموث"، نشأ عن عامل ممرض خرج من جثة ماموث مجمدة، وأصاب باحثين وطاقم تصوير كانوا قد عثروا عليها.
ورغم أن التمرين افتراضي بالكامل، إلا أن العلماء حذّروا من أن الخطر الكامن في ذوبان التربة الصقيعية بسبب تغير المناخ واقعي تماما، وقد يؤدي إلى إطلاق فيروسات وبكتيريا مجمدة منذ آلاف السنين.
وبيّنت الدراسات أن الميكروبات المجمدة يمكن أن تظل خاملة لعشرات الآلاف من السنين في جثث الحيوانات المنقرضة أو التربة القطبية. وإذا خرجت هذه المسببات المرضية إلى البيئة، فلن تكون لدى البشر أي مناعة طبيعية لمواجهتها، تماما كما حدث عند ظهور فيروس كورونا.
وفي "تمرين بولاريس"، صُمم سيناريو انتشار فيروس "جدري الماموث" ليحاكي فيروسا قاتلا شبيها بالجدري التقليدي وجدري القرود المعاصر، مع معدل وفيات متوسط بين الاثنين. وشارك في التمرين خبراء من دول عدة، بينها الدنمارك والصومال وقطر وألمانيا والسعودية. وقُدمت لكل دولة رواية مختلفة للسيناريو، حيث ظهرت حالات الإصابة بجدري الماموث في سياقات متنوعة: من سفينة سياحية إلى تجمعات جماهيرية أو عائلات.
وقد استمر التمرين لمدة يومين، لكنه حاكى انتشارا افتراضيا للفيروس على مدار 3 أسابيع. وفي اليوم الثاني، واجه المشاركون الخبراء عقبات تمثّلت في خلافات سياسية وتفاوت في الاستجابة الدولية، إذ قررت بعض الدول إغلاق حدودها بالكامل، بينما اعتمدت دول أخرى على تتبع الحالات والمخالطين.
ورغم التعقيدات، نجح الفريق في النهاية باحتواء الفيروس، لكن منظمة الصحة العالمية أكدت أن سيناريو الواقع سيكون أصعب بكثير، خاصة في ظل الانقسامات السياسية مثل انسحاب الولايات المتحدة والأرجنتين من المنظمة في وقت سابق من العام.
ويحذّر العلماء من أن ذوبان التربة الصقيعية بفعل الاحتباس الحراري يُطلق بالفعل كائنات دقيقة مجمدة لم يعرفها الطب الحديث. ففي عام 2014، أُعيد إحياء فيروسات من تربة صقيعية سيبيرية قُدرت أعمارها بآلاف السنين، وأثبتت قدرتها على إصابة الخلايا الحية.
وفي 2023، نجح العلماء في إحياء فيروس أميبي ظل متجمدا لمدة 48500 عام.
وفي ظل تصاعد عمليات التنقيب عن الحيوانات المنقرضة المجمدة، سواء لأغراض علمية أو تجارية، يزداد خطر إطلاق فيروسات منسية. وبينما يسعى العالم للتأهب للأوبئة المستقبلية، تبدو الحاجة ملحّة إلى تعاون دولي فعّال لمواجهة التهديدات القادمة من أعماق الجليد.